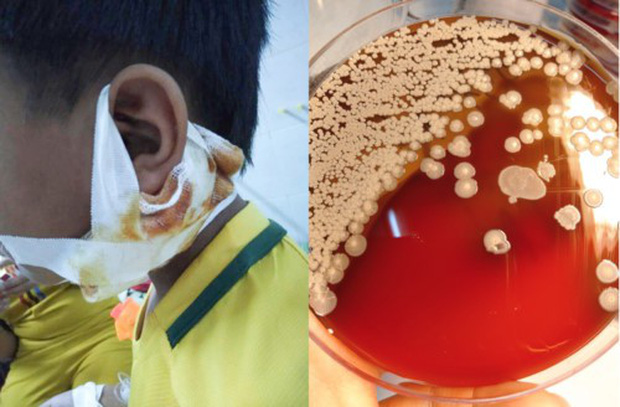
Vi khuẩn ăn thịt người thường có trong bùn, đất, nước bị ô nhiễm.

-
 Diện mạo thay đổi và lời nhắn nhủ gây xúc động của Ngân 98 sau hơn 8 tháng bị tạm giam
Diện mạo thay đổi và lời nhắn nhủ gây xúc động của Ngân 98 sau hơn 8 tháng bị tạm giam -
 Tháng 7 bùng nổ với 4 bộ phim Hàn Quốc đáng chờ đợi, quy tụ dàn sao đình đám
Tháng 7 bùng nổ với 4 bộ phim Hàn Quốc đáng chờ đợi, quy tụ dàn sao đình đám -
 Nữ thủ khoa tổ hợp A01: Đạt điểm SAT cao nhất thế giới, trúng tuyển ĐH top Hàn Quốc và mê chơi game
Nữ thủ khoa tổ hợp A01: Đạt điểm SAT cao nhất thế giới, trúng tuyển ĐH top Hàn Quốc và mê chơi game -
 Thân thế thủ khoa toàn quốc khối A00, bật mí bí quyết đạt 3 điểm 10 và ngôi trường định đăng ký
Thân thế thủ khoa toàn quốc khối A00, bật mí bí quyết đạt 3 điểm 10 và ngôi trường định đăng ký -
 Nguyên điều tra viên hình sự cao cấp: Vụ phát hiện bộ xương nam MC ở TP HCM là một vụ "án mờ"
Nguyên điều tra viên hình sự cao cấp: Vụ phát hiện bộ xương nam MC ở TP HCM là một vụ "án mờ" -
 Nghi vấn rạn nứt giữa Hoa hậu Thanh Thủy và Trịnh Thăng Bình sau dòng trạng thái lạ
Nghi vấn rạn nứt giữa Hoa hậu Thanh Thủy và Trịnh Thăng Bình sau dòng trạng thái lạ -
 Vụ shipper bị đánh nhập viện vì đơn hàng hơn 2 triệu đồng: Nguyên nhân yêu cầu hoàn tiền bị từ chối
Vụ shipper bị đánh nhập viện vì đơn hàng hơn 2 triệu đồng: Nguyên nhân yêu cầu hoàn tiền bị từ chối -
 Ô tô lao lên vỉa hè tông 2 người ở Lào Cai rồi rời hiện trường, danh tính chủ phương tiện lộ diện
Ô tô lao lên vỉa hè tông 2 người ở Lào Cai rồi rời hiện trường, danh tính chủ phương tiện lộ diện -
 Chính thức mở hệ thống đăng ký nguyện vọng đại học năm 2026: Những lưu ý trọng tâm thí sinh cần biết
Chính thức mở hệ thống đăng ký nguyện vọng đại học năm 2026: Những lưu ý trọng tâm thí sinh cần biết -
 Va chạm giữa ô tô và xe máy trong đêm trên đường Hồ Chí Minh, 3 người thương vong
Va chạm giữa ô tô và xe máy trong đêm trên đường Hồ Chí Minh, 3 người thương vong
Gia đình
17/09/2019 02:51Nghệ An: Sức khỏe 3 bệnh nhi nhiễm vi khuẩn ăn thịt người chuyển biến tốt

Bệnh nhi bị Whitmore chuyển biến tốt, 1 cháu đã xuất viện
Ca bệnh Whitmore (nhiễm vi khuẩn ăn thịt người) mới nhất được đưa tới bệnh viện được đưa đến bệnh viện Sản nhi Nghệ An vào ngày 13/9 vừa qua.
Cháu bé tên Hà Bảo L. (8 tuổi, trú huyện Nghĩa Đàn, Nghệ An) nhập viện trong tình trạng sốt, đau tai, đau vùng má.
Mẹ cháu L., chị Hà Thị Cúc cho biết: Ngày 1/9, cháu kêu đau ở vùng má và được gia đình đưa đến bệnh viện huyện kiểm tra. Cháu được chẩn đoán cháu bị quai bị, cho thuốc uống và điều trị theo bệnh lý này.
“Tuy nhiên, sau 3 ngày các triệu chứng của cháu vẫn không đỡ, gia đình yêu cầu bác sĩ kiểm tra lại, sau đó kết luận cháu bị áp xe viêm màng tai. Điều trị thêm một thời gian thì cháu được chuyển tuyến đến Bệnh viện Sản nhi Nghệ An”, chị Cúc nói.
Tại Bệnh viện Sản nhi, các bác sĩ cho xét nghiệm máu, cấy mủ thì xác định cháu Liêu mắc bệnh Whitmore.
Bác sĩ Nguyễn Quang Hà , Khoa Răng – Hàm – Mặt (Bệnh viện Sản Nhi Nghệ An) cho biết: Bệnh nhi được điều trị theo đúng phác đồ và hiện sức khỏe đã ổn định.
Trước đó trong 2 tháng 7 - 9/2019, bệnh viện Sản nhi Nghệ An tiếp nhận, phát hiện và điều trị cho 3 trường hợp mắc chứng bệnh nhiễm vi khuẩn ăn thịt người gồm: Bệnh nhi Nghiêm Thanh T. (14 tuổi, trú huyện Đức Thọ, Hà Tĩnh) điều trị 50 ngày, đã xuất viện. Hai bệnh nhi Hoàng Văn C. (10 tuổi, trú xã Thanh ngọc, huyện Thanh Chương), Nguyễn Công H. (11 tuổi, trú xã Công Thành, huyện Yên Thành).
Sau 50 ngày điều trị, cháu Nghiêm Thanh T. đã khỏi bệnh và đã xuất viện. Hai cháu C. và H. vẫn đang được theo dõi và điều trị tại khoa Tai Mũi Họng.
Các bác sĩ cũng cho biết, cả 3 trường hợp trước khi nhập viện đều đã được điều trị ở tuyến dưới theo chẩn đoán bị bệnh quai bị nhưng không khỏi. Khi chuyển đến bệnh viện thì tình trạng bệnh nhi đã nặng nên thời gian điều trị kéo dài. Tuy nhiên, hiện sức khỏe các cháu đều ổn định và chuyển biến tốt.
Bệnh nhân cần kiên trì điều trị
Theo bác sĩ Nguyễn Thị Huyền Ngân, Khoa Tai Mũi họng - Bệnh viện Sản Nhi Nghệ An, bệnh Whitmore là một bệnh lây nhiễm gây ra bởi vi khuẩn Gram âm Burkholderia pseudomallei (trước đây có tên gọi là Pseudomonas pseudomallei) gây bệnh cảnh nhiễm trùng máu.
Bệnh không có triệu chứng rõ ràng và dễ nhầm lẫn với nhiều bệnh khác, nhưng có thể gây tử vong nhanh chóng. Tỷ lệ tử vong của bệnh Whitmore có thể lên đến 50% - 60%. Hiện tại đang mùa mưa, là thời điểm thuận lợi để vi khuẩn whitmore phát triển.
Tuy nhiên, các triệu chứng lâm sàng của bệnh cũng rất mơ hồ, chẩn đoán khó nên dễ bị chẩn đoán nhầm sang các bệnh lý khác như: Quai bị, viêm phổi, nhiễm khuẩn da mô mềm, nhiễm khuẩn xương khớp, nhiễm khuẩn huyết do tụ cầu, liên cầu...
Ngay cả khi được khẳng định chẩn đoán bệnh Whitmore, việc điều trị cũng hết sức khó khăn. Bệnh nhân thường phải dùng kháng sinh tấn công liều cao tĩnh mạch kéo dài liên tục trong ít nhất khoảng 2 - 4 tuần. Sau đó dùng kháng sinh duy trì khoảng từ 3 đến 6 tháng.
Nếu không được điều trị đúng liều, đúng phác đồ và theo dõi liên tục thì bệnh dễ tái phát. Sức khỏe bệnh nhân suy kiệt dần và vẫn có thể tử vong dù đã được chẩn đoán đúng.
Bác sĩ Ngân cũng lưu ý: “Việc điều trị bệnh thời gian dài, tốn kém nên không ít bệnh nhân đã bỏ cuộc. Đây cũng là một trong là những nguyên nhân dẫn đến việc điều trị không đạt hiệu quả cao nhất, và tỉ lệ tử vong do whitmore cao”.
Ông Nguyễn Văn Định – Giám đốc Trung tâm Y tế dự phòng Nghệ An bệnh Whitmore nguy hiểm nhưng người dân không vì vậy mà quá hoang mang. Vi khuẩn ăn thịt người không lây từ người qua người. Những trường hợp mắc bệnh vừa qua trên địa bàn là những ca bệnh đơn lẻ không gây ra dịch bệnh.
Tuy nhiên, căn bệnh này rất nguy hiểm nếu không phát hiện kịp thời cũng như điều trị đúng phác đồ. Vi khuẩn gây bệnh này có trong bùn, đất và lây nhiễm chủ yếu do vùng da bị tổn thương tiếp xúc trực tiếp với vi khuẩn.
Vì vậy, người dân khi lao động tiếp xúc với môi trường đất, nước nhiễm khuẩn cần dùng các vật dụng bảo hộ như đeo găng tay, khẩu trang… Nếu có trầy xước ngoài da cần vệ sinh, sát trùng cẩn thận tránh nhiệm bệnh. Khi có các triệu chứng bất thường thì đến ngay cơ sở y tế để kiểm tra.
Theo Hố Lài (Giáo Dục Và Thời Đại)








- Đội tuyển Việt Nam sang Hàn Quốc tập huấn, HLV Kim Sang-sik mang theo lực lượng mạnh nhất (15:38)
- Bảng giá iPhone cũ tháng 7: Giảm thủng đáy, iPhone 14 chỉ từ 10 triệu đồng, iPhone 13 cũ rẻ như cho (15:34)
- Diện mạo thay đổi và lời nhắn nhủ gây xúc động của Ngân 98 sau hơn 8 tháng bị tạm giam (15:31)
- Thượng đỉnh tiền số và tài sản tăng vọt: Tổng thống Donald Trump phá vỡ im lặng về khoản thu nhập 1,2 tỷ USD (15:15)
- 5 dấu hiệu xuất hiện khi ngủ cảnh báo tim, thận đang gặp vấn đề: Nhiều người tưởng do tuổi tác nên bỏ qua (15:15)
- Doanh thu gần 835 tỷ đồng nhưng bị cáo buộc trốn thuế hơn 12,5 tỷ, nữ chủ shop đồ hiệu bị đưa ra xét xử (43 phút trước)
- Tháng 7 bùng nổ với 4 bộ phim Hàn Quốc đáng chờ đợi, quy tụ dàn sao đình đám (44 phút trước)
- Nhận định Thụy Sĩ vs Algeria: Bản lĩnh lên tiếng (45 phút trước)
- Nữ thủ khoa tổ hợp A01: Đạt điểm SAT cao nhất thế giới, trúng tuyển ĐH top Hàn Quốc và mê chơi game (50 phút trước)
- Nam thanh niên bị nước cuốn khi chạy xe máy qua cầu tạm (1 giờ trước)
Bài đọc nhiều













